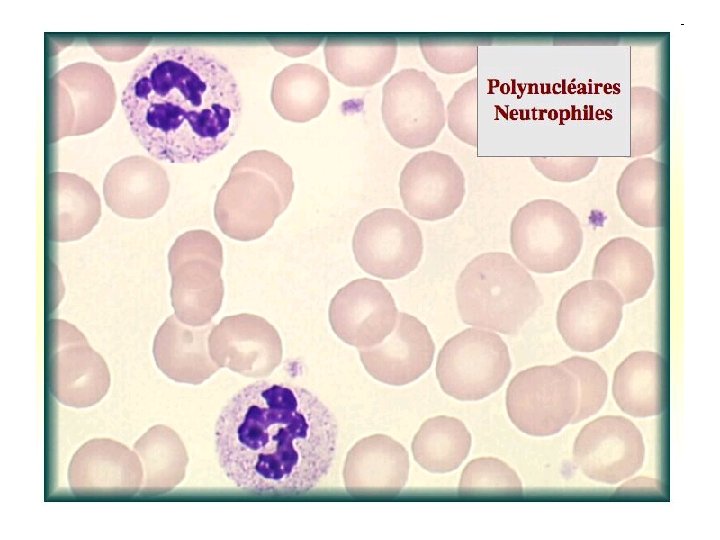
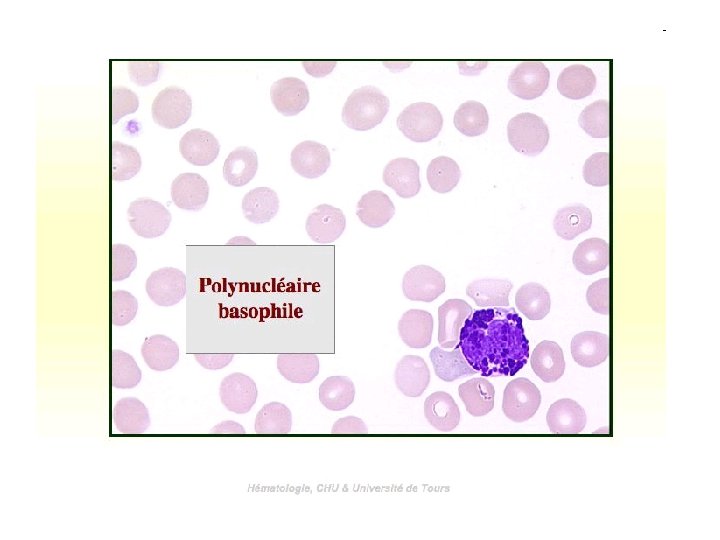

Anglais leucocyte amricain leukocyte Terme issu du Grec

- Slides: 63
* Anglais : leucocyte, américain : leukocyte. * Terme issu du Grec : leukos : blanc et kutos : cellule. * Terme issu du Latin : globulus : petite boule.
Définition Cellule du sang humain contenant un noyau, appelée également leucocyte et jouant essentiellement un rôle dans la défense de l'organisme contre les agents étrangers. On distingue les mononucléaires (lymphocytes et monocytes) des polynucléaires. Le terme globule désigne une boule de forme sphérique et de petite taille. Ce terme est utilisé pour désigner les globules rouges (hématies), les globules blancs (leucocytes), les globules polaires de Robin qui sont des petites cellules constituées lors de la division des ovocytes (œuf provenant de l'ovaire) au moment de l'ovogenèse (fabrication de l'ovule dans l'ovaire) qui dégénéreront ensuite. Les leucocytes ont été étudiés par Charles Robin au 19 e siècle.
Classification On distingue : 1. Les leucocytes polynucléaires (ou granulocytes) comprenant : Les polynucléaires neutrophiles, de forme généralement sphérique, constituant la moitié de la population totale des globules blancs. Ils ont un volume double de celui des globules rouges. Les granulocytes neutrophiles possèdent un mélange de protéines ayant les caractéristiques de celles des antibiotiques : on les appelle à juste titre les défensines. Leur noyau est composé de 3 à 6 lobes, d'où leur nom de polynucléaires. Grâce à des enzymes, ils possèdent une activité de phagocytose, c'est-à-dire de digestion des corps étrangers et plus particulièrement des bactéries.
Les neutrophiles phagocytent très activement les bactéries et sont présents en nombre élevé dans le pus des plaies. Malheureusement, ces cellules sont incapables de renouveler les lysosomes utilisés dans la digestion des microbes et meurent après en avoir phagocyté quelques-uns.
Les polynucléaires éosinophiles représentent 2 à 4 % de la totalité des globules blancs. Leur noyau comprend généralement 2 lobes. Leur rôle consiste à assurer la défense contre certains parasites (ténia, oxyures, douve, schistosome, etc. ) trop gros pour être phagocytés (digérés). Ces parasites pénètrent dans l'organisme par l'intermédiaire du tube digestif (poisson cru, viande de porc) ou à travers la peau, et vont se loger le plus souvent dans la muqueuse du tube digestif (intestins) ou des poumons. C'est là que les polynucléaires éosinophiles se chargent de leur destruction en libérant des enzymes qui vont permettre leur digestion. Les polynucléaires éosinophiles interviennent également dans les réactions d'allergie en détruisant les protéines étrangères (allergènes) et les complexes (associations) antigène-anticorps à l'origine des allergies.
Les polynucléaires basophiles sont les moins nombreux des globules blancs (0, 5 % de la population totale de leucocytes). Cette variété de globules blancs contient de l'histamine, qui est un médiateur (messager) sécrété pendant la réaction inflammatoire et au cours de l'allergie. L'histamine entraîne la vasodilatation (augmentation du calibre des vaisseaux) et attire les autres globules blancs dans la région concernée par l'inflammation (chimiotactisme) Les basophiles sécrètent des substances anticoagulantes et vasodilatatrices comme les histamines et la sérotonine. Malgré leur capacité phagocytaire, leur principale fonction est de sécréter les substances qui servent à la médiation de la réaction d'hypersensibilité.
2. Les leucocytes mononucléaires (ou agranulocytes) comprenant : Les lymphocytes, relativement nombreux mais peu abondants dans la circulation sanguine. On les trouve essentiellement dans les ganglions lymphatiques, la rate, etc. où ils jouent un rôle important dans l'immunité. Il existe 2 types de lymphocytes : les lymphocytes T. appelés également lymphocytes T. tueurs ou lymphocytes T. suppresseurs. Ils participent à la réaction immunitaire en combattant spécifiquement les cellules infectées par un virus ainsi que les cellules cancéreuses lymphocytes B. qui donnent naissance aux mastocytes fabricants les anticorps (immunoglobulines) qui sont libérés dans le sang. les monocytes sont les plus gros des leucocytes. Ils sont capables de se transformer en macrophagocytes ayant un potentiel de phagocytose extraordinaire mais également une mobilité très élevée.
Les lymphocytes sont des cellules qui, outre leur présence dans le sang, peuplent aussi les tissus lymphoïdes et les organes de même que la lymphe circulant dans les vaisseaux lymphatiques. Les organes lymphoïdes comprennent le thymus, la moelle osseuse (dans la bourse séreuse des oiseaux), la rate, les nodules lymphoïdes, les amygdales palatines, les plaques de Peyer et les tissus lymphoïdes du système respiratoire et du tube digestif. La plupart des lymphocytes qui circulent dans le sang se trouve en état de repos. Ils ressemblent à de petites cellules ayant un noyau circulaire compact qui occupe la quasi totalité du volume cellulaire. Par conséquent, le cytoplasme est beaucoup réduit. Les lymphocytes des organes et des tissus lymphoïdes peuvent être activés de différente manières par suite d'une stimulation antigénique. Dans le sang, les lymphocytes comptent pour de 20 à 40 % de tous leucocytes et sont un peu plus gros que les globules rouges. Les lymphocytes sont les principaux éléments du système immunitaire, qui assure la défense contre les attaques de micro-organismes pathogènes comme les virus, bactéries, champignons et protistes. Les lymphocytes produisent aussi des anticorps et les disposent sur leur membrane. L'anticorps est une molécule capable de se lier à d'autres molécules de forme complémentaire appelés antigènes, et de les reconnaître. Les anticorps sont codifiés par des gènes, comme le sont toutes les protéines. En fonction du mécanisme de recombinaison de certains de ces gènes, chaque lymphocyte produit des anticorps d'une forme particulière.
Ainsi, les lymphocytes exécutent une action dite spécifique dans la mesure où chacun d'entre eux reconnaît uniquement l'antigène complémentaire. Même si chacun des lymphocytes est si sélectif qu'il ne reconnaît qu'une seule molécule, le nombre de lymphocytes en circulation est si élevé qu'ensemble ils peuvent reconnaître la quasi totalité des substances présentes dans l'organisme, qu'il s'agisse des siennes ou de substances étrangères. On parle ici de la reconnaissance de centaines de millions de molécules différentes. Les cellules du système immunitaire, principalement les lymphocytes, collaborent entre eux pour activer, amplifier ou préciser la réaction immunitaire. Pour ce faire, il existe divers types de lymphocytes ayant des fonctions différentes : les lymphocytes T et B. Lorsque les cellules B sont activées, elles se reproduisent rapidement (sélection clonale) et deviennent des plasmacellules sécrétant un nombre élevé d'anticorps dans le flux sanguin (réponse humorale). Lorsque des anticorps libres rencontrent des micro-organismes ayant une forme complémentaire (épitopes), ils se lient à ces derniers pour constituer des complexes qui immobilisent ces micro-organismes. Ultérieurement, d'autres cellules qui ne sont pas spécifiques, mais qui peuvent reconnaître les anticorps, phagocytent ces complexes. À leur tour, les cellules T se divisent en trois catégories : cytotoxiques (Tc), auxiliaires (Th) et suppresseurs (Ts). Même les lymphocytes cytotoxiques se reproduisent rapidement quand ils sont activés. Ils ne libèrent pas d'anticorps dans le flux sanguin, mais les retiennent sur leur membrane et s'en servent pour reconnaître les cellules principalement de leur propre organisme qui sont infectés par un virus ou des cellules tumorales. Les lymphocytes cytotoxiques tuent les cellules en libérant des perforines, des substances qui causent des lésions dans la membrane de la cellule cible et provoquent sa mort par lyse osmotique (réponse à médiation cellulaire). Des lymphocytes auxiliaires sont nécessaires pour activer les lymphocytes B et Tc qui, même s'ils reconnaissent les agents étrangers, s'engagent rarement dans une action directe. Les lymphocytes suppresseurs réduisent l'intensité de la réaction immunitaire.
Toutefois, le système immunitaire ne doit pas attaquer les cellules de son corps car la réponse auto-immune peut endommager l'organisme et entraîner sa mort. Comment le système immunitaire arrive-t-il à faire la distinction entre ses propres composantes et un corps étranger ? Les lymphocytes B et Tc ayant reconnu un antigène ne passent pas à l'action, mais qu'ils doivent plutôt être activés par un lymphocyte auxiliaire. Peu de temps après avoir été produits, une partie des nouveaux lymphocytes passe par le thymus où ils deviennent des lymphocytes T. Ces cellules se comparent alors à tous les antigènes de l'organisme (autoantigènes). Il semble que les lymphocytes Th qui reconnaissent un antigène meurent, car ils sont encore immatures. Ainsi, vu que les lymphocytes T auxiliaires auto-réactifs sont éliminés, seuls les lymphocytes B et Tc ayant reconnus des antigènes étrangers peuvent être activés. Le système de cytotoxicité cellulaire dont les cellules T auxiliaires servent à la médiation a évolué comme mécanisme de défense contre leurs propres cellules infectées, modifiées ou aberrantes. En fait, les lymphocytes B et Tc peuvent s'activer eux-mêmes contre les bactéries, même sans la participation des auxiliaires.
En plus de produire des anticorps et tuer les cellules étrangères, les lymphocytes B et Tc activés se reproduisent rapidement. Au cours de la division cellulaire, des redéploiements se produisent souvent dans la séquence des gènes qui codifient les anticorps. Ainsi, les anticorps de la nouvelle cellule prennent une forme légèrement différente de celle de son "parent mitotique". Si cette nouvelle forme convient mieux à l'antigène, la cellule est amenée à se réproduire davantage. La nouvelle génération de clones est donc plus efficace et, à son tour, peut générer des variétés encore plus sélectives. Ce processus, tout comme celui de la sélection clonale, rendent la réaction immunitaire de plus en plus efficace. Enfin, le système immunitaire produit des cellules mémoire, c'est-à-dire des lymphocytes désactivés, mais prêts à se réactiver lors d'une nouvelle rencontre avec le même antigène. Outre les cellules Th et B, une troisième population de lymphocytes dans le sang périphérique et les organes lymphoïdes n'est pas pourvue de récepteurs d'antigènes. Ces lymphocytes assurent une fonction de défense non spécifique qui n'est pas activée par les lymphocytes Th. Ils constituent la composante la plus ancienne du système immunitaire et sont caractérisés par leur activité cytotoxique. Pour ces raisons, on les nomme NK (pour « natural killers » , ou tueurs naturels). En plus de tuer les virus, les bactéries et les cellules infectées et néoplasiques, ces lymphocytes règlent la production d'autres cellules sanguines comme les érythrocytes et les granulocytes.
Les monocytes se multiplient et s'activent en cas d'infection chronique (durant dans le temps) comme la tuberculose entre autres. Ils interviennent très efficacement dans la lutte contre les virus et contre certains parasites et bactéries situés à l'intérieur des cellules. Ils participent, avec les lymphocytes, à la défense de l'organisme par l'intermédiaire du système immunitaire en « lançant » ceux-ci.
Les monocytes sont les précurseurs des macrophages. Ce sont des cellules sanguines plus grosses qui, après avoir atteint leur maturité dans la moelle osseuse, entrent dans le flux sanguin où elles demeurent pendant de 24 à 36 heures. Elles migrent ensuite vers les tissus conjonctifs, où elles deviennent des macrophages et se déplacent dans les tissus. S'ils parviennent au site d'une inflammation, les monocytes migrent rapidement à partir du vaisseau sanguin et se lancent dans une intense activité phagocytaire. La phagocytose n'est pas le rôle exclusif de ces cellules car elles ont aussi une activité de sécrétion intense. Elles produisent des substances exerçant des fonctions de défense comme les lysozymes, les interférons et des substances qui modulent la fonctionnalité d'autres cellules. Les macrophages participent à la défense immunitaire. Ils exposent les molécules de corps digérés sur leur membrane et les présentent à des cellules plus spécialisées, comme les lymphocytes B et T auxiliaires.
Chaque type de leucocyte est présent dans le sang en proportions différentes : Neutrophiles, de 50 à 70 % Eosinophiles, de 2 à 4 % Basophiles, de 0, 5 à 1 % Lymphocytes, de 20 à 40 % Monocytes, de 3 à 8 %
Hemocytomètre
Les techniques de répartitions des leucocytes: automatique et manuelle Répartition automatique Les analyseurs modernes d'hématologie sont équipés d'un cytomètre de flux qui différencie et ainsi compte les différentes familles de leucocytes. Les graphes ci-dessous montrent des nuages de points dont chaque point correspond à un leucocyte compté et la couleur correspond à la famille identifiée (par exemple, en jaune; les neutrophiles, en bleu les lymphocytes, en rose les monocytes, etc…) Les chiffres à gauche de l'écran sont les résultats chiffrés des mesures et des différents calculs.
L'hémostase est un processus physiologique qui regroupe l'ensemble des phénomènes (1) déclenchés par une lésion vasculaire et (2) destinés à limiter les pertes sanguines au niveau de la brèche vasculaire a) Dans un vaisseau intact, le sang reste fluide. Les plaquettes ne sont pas activées par l'endothélium. b) Un traumatisme crée une brèche vasculaire qui rompt la continuité de la mono couche de cellules endothéliales et expose les structures sous endothéliales au contact du sang. c) Ce contact entraîne l'adhésion et l'activation des plaquettes au site de la lésion ainsi que l'activation de la coagulation conduisant à la formation de fibrine : le thrombus fait de plaquettes agrégées et de fibrine comble la brèche vasculaire et arrête le saignement, et permet la cicatrisation. Le processus de fibrinolyse permettra la redissolution du caillot et la reperméabilisation du vaisseau. Lorsqu'une lésion entraîne la rupture de la continuité de la couche endothéliale, le sang vient au contact du sous endothélium et le processus d'hémostase est déclenché. C'est un phénomène localisé, rapide grâce à une amplification locale, et régulé de façon à ne pas obstruer tout le vaisseau. Il fait intervenir les plaquettes, le vaisseau et les protéines de la coagulation.
Schématiquement on distingue : hémostase primaire (adhésion/activation/agrégation des plaquettes) et activation de la coagulation plasmatique, mais les 2 phénomènes sont simultanés et interdépendants.
http: //imagerie-cv. univlyon 1. fr/WEB_CARDIO/documents/Documents_references/polybiomeca/biomec 15. htm
La cellule endothéliale est non thrombogène : elle protège de l'activation des plaquettes, elle régule négativement la coagulation et synthétise des protéines du système fibrinolytique. Le sous endothélium est thrombogène : il va permettre l'adhésion des plaquettes et l'activation de la coagulation. Il est composé de macromolécules synthétisées par la cellule endothéliale sus jacente : collagènes, microfibrilles, fibronectine, thrombospondine, facteur Willebrand, glycosaminoglycanes.
2) LES PLAQUETTES( les trombocytes) Formées dans la moëlle osseuse à partir du mégacaryocyte, ce sont des structures discoïdes, anucléées (150 à 400 G/l). Leur durée de vie est de 8 à 10 jours. Après leur mort, elles sont phagocytées par les macrophages essentiellement de la rate, du foie, de la moëlle osseuse. Valeurs normales: 200000 -400000/mmc sang <200000 /mmc sang - trombocytopénie -----des hémorragies > 400000/mmc sang -trombocytose Des granules sont présents dans le cytoplasme des plaquettes : - Les granules alpha contiennent de nombreuses protéines. Certaines sont spécifiques de la plaquette (facteur 4 plaquettaire, b thromboglobuline) ou non (fibronectine, thrombospondine, fibrinogène, facteur Willebrand et autres facteurs de la coagulation, des facteurs de croissance, des inhibiteurs de la fibrinolyse, des immunoglobulines). - Les granules denses contiennent de l'ADP, du calcium et de la sérotonine. Le contenu des granules sera sécrété via le système canaliculaire ouvert lors de l'activation. La membrane des plaquettes est formée d'une bicouche de phospholipides dans laquelle sont insérés des récepteurs pour un certain nombre de molécules (ADP, collagène, thrombine. . . ). Certains de ces récepteurs deviennent fonctionnels uniquement après activation des plaquettes (ex : GPIIb IIIa).
3) LE FACTEUR WILLEBRAND (FW) Sécrété par la cellule endothéliale, Il est relargué a la fois dans le sous endothélium et le plasma. Le FW du sang circulant n'a pas la conformation requise pour se fixer à la plaquette, il circule lié au facteur VIII qu'il stabilise. Le FW est également présent dans les granules alpha des plaquettes. Le degré de polymérisation du FW est fonction de sa localisation: les multimères de grande taille sont présents dans le sous endothélium où ils ont la conformation nécessaire à leur fixation sur la plaquette, le FW des plaquettes qui est aussi sous forme de multimères n'intervient qu'apres l'activation plaquettaire.
4) LE FIBRINOGENE Synthétisé par le foie, il est présent dans le plasma et les granules a des plaquettes. Il est à la fois indispensable pour l'hémostase primaire où il conditionne l'agrégation des plaquettes, et pour la coagulation où la thrombine, enzyme produite lors de l'activation de la coagulation, le transforme de protéine soluble en un réseau insoluble.
L'hémostase est le mécanisme amenant à l'arrêt du saignement lorsqu'un vaisseau a été blessé. L'hémostase comporte 3 temps : * Le temps pariétal : composé du temps vasculaire et du temps plaquettaire. * Le temps plasmatique. * Le temps thrombodynamique.
http: //www. authorstream. com/Presentation/Sciencedzaguet 166811 -physiologie-de-hemostase-1 -physiologiehemostaseentertainment-ppt-powerpoint/
Résistance globulaire Cet examen consiste à mélanger les globules rouges d’un sujet dans des solutions salées de concentration croissante (dite de " tonicité " croissante) et à observer à partir de quelle concentration les globules rouges sont détruits (hémolyse). Ce test permet d’apprécier le degré de fragilité des globules rouges. Normalement, l’hémolyse commence vers 4, 4 pour mille de chlorure de sodium (Na. Cl) et est complète à 3, 4 pour mille de Na. Cl. Une diminution de la résistance dite " résistance osmotique " est observée au cours de certaines anémies hémolytiques dites autoimmunes (les globules rouges sont détruits par des anticorps que le sujet fabrique lui-même). La résistance osmotique est en revanche augmentée au cours d’autres anémies héréditaires appelées thalassémies.